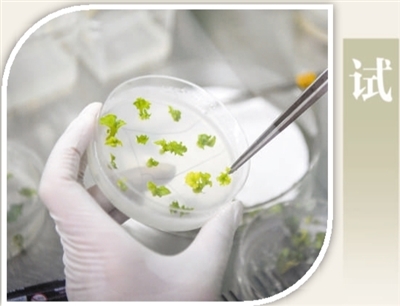

浙江省湖州市安吉县农高区,施工人员正在建设现代数字农业产业园。这一产业园集现代育种、农业生产、技术示范为一体,将助推当地农业技术发展。夏鹏飞摄(影像中国)

贵州省黔东南苗族侗族自治州岑巩县关庄村芥菜种植基地,村民们在采收芥菜。胡攀学摄(人民视觉)

贵州省铜仁市松桃苗族自治县普觉镇真旗屯村,农民在收获水稻后,感受丰收的喜悦。 龙元彬摄(影像中国)

浙江省杭州市淳安县千岛湖国家级水产种质资源保护区内,渔民在进行“巨网捕鱼”。谢航凯摄(影像中国)

近年来,山东省威海市积极拓展海洋水产种质资源,保障海产品安全有效供给。图为渔船在威海市合庆码头整装待发。记者 伊霄 摄 数据来源:农业农村部,本报记者常钦采访整理

中国科学院昆明植物研究所中国西南野生生物种质资源库采集员在珠峰大本营采集种子标本。 蔡 杰摄(人民视觉)

在位于海南省三亚市的四川省农业科学院水稻高粱所科研基地里,科研人员在进行水稻新品种选育。 何海洋摄(人民视觉)
天津市农业科学院种质资源与生物技术研究所,科研人员在开展黄瓜种质遗传转化筛选试验。 新华社记者 孙凡越摄

山东省青州市益都街道北河东村一处蔬菜育种试验基地内,工人在准备蔬菜繁殖所需的保温膜。 王继林摄(影像中国)

江苏省昆山市陆家镇未来农业示范园中,技术人员在采摘新选育出的西红柿品种。 许丛军摄(人民视觉)
习近平总书记在广东考察时强调,种业是现代农业、渔业发展的基础,要把这项工作做精做好。
一粒种子,可能不足0.1克,却是农业现代化的基础。种业处于农业整个产业链的源头,是建设现代农业的标志性、先导性工程。无论是野外探寻,扩充种质资源库,还是创制材料,育种、制种,乃至于DNA提取、基因分析、分子标记做检测……从种质资源收集与保护,到突破性品种选育,再到前沿育种技术研发,各个环节久久为功,推动我国现代种业不断发展,让更多良种走向沃野。
如今,我国国家级种业基地加快布局,由216个农作物基地、262个畜禽育种场、91家水产原良种场组成的“国家队”,供种保障能力由70%提高到75%。节水小麦、优质水稻品种选育取得新突破,农作物良种覆盖率达96%以上,保障了中国粮主要用中国种。






